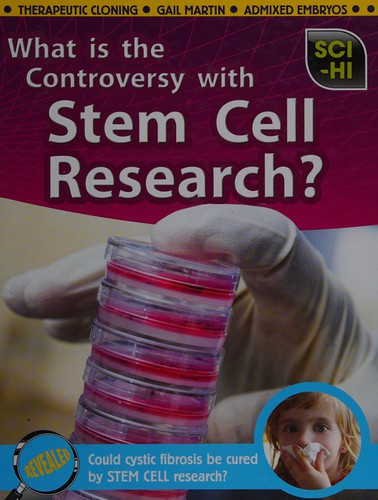
What is the controversy with stem cell research?

Role of the cerebellum and basal ganglia in voluntary movement

Potato diseases in San Joaquin County, California

Water pollution: a selected bibliography of California and U. S. government documents

Theories of chemistry

Applied biochemistry

What is the controversy with stem cell research?

Catálogo da Flora de Galicia

Geology of our western national parks and monuments

Report on Paleontology

Phase II regional water, sewerage, and drainage program

The Coanda effect with jet displacement over planar, concave, and convex walls

Close-range photogrammetry meets machine vision

A new subspecies of Caiman sclerops from Colombia.

Meteorololgy and Flight

A visual approach and landing simulator system

Occurrence and removal of volatile organic chemicals from drinking water

Pollution

Static diffusion models of the upper atmosphere with empirical temperature profiles.

A System of surgery v.3

Jane's aerospace dictionary

Polymer Adhesion

Ultra micro weight determination in controlled environments

Spring flora of Oklahoma

Aids to obstetrics and gynecology

Anwendung der elliptischen Funktionen auf durch algebraische Funktionen ...

Obstetrics and gynecology

Annual report and statistics of the meteorology of the city of Oakland, California, for the year ...

A System of medicine

Nutrition status of Mexican American children in the United States

Quality Criteria for Water Reuse

The cranial anatomy of the mail-cheeked fishes.

Reptiles and Amphibians

Intertidal and littoral ecosystems

Diccionario de términos y expresiones hematológicas

Dynamics and control of the body fluids

Patterns and problems in world agriculture

Silvical characteristics of rock elm (Ulmus thomasii)

Recommended minimum water well construction and sealing standards for the protection of ground water quality, Alameda County.

Die Magensonde: Die Geschichte ihrer Entwicklung und ihre Bedeutung in diagnostisch ...

Comparative Chemical Mutagenesis (Environmental Science Research)

Assolements et culture du sol dans l'est du Canada

Annales des Sciences Naturelles